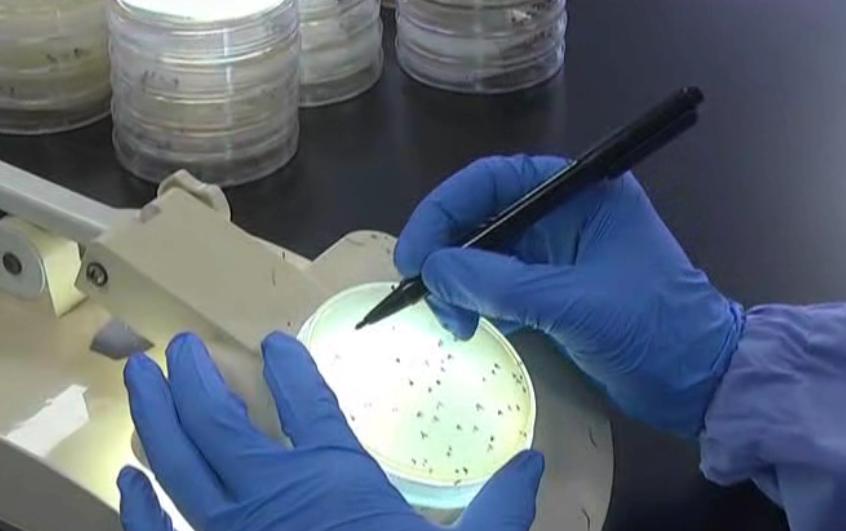
市面上假的美心月饼,你买到过哪些离谱的劣质产品

离中秋国庆放假只剩7天了
送人的月饼准备好了吗?
身边好多小伙伴都打算网购月饼回家
但是网购月饼的要注意了!
你吃的可能是假月饼!

网红美心流心月饼
某批发平台只需几十元!
最近几年除了传统月饼
而网红美心的流心月饼
同样备受大家喜爱
吃上去口感绵密,流心馅料有浓郁奶黄味
甜而不腻,适合一家大小

一盒流心奶黄月饼
在美心官方旗舰店售价为358元
即使叠加优惠券
一盒也要328元

但是我们发现
在阿里巴巴批发平台上
一家名为深圳市彼酷男装服饰
商贸有限公司的网店页面里看到
港版美心流心月饼的标价
根据批发量分为60元、80元、90元三种价位

这些市场上单价300多元的月饼
零售和批发之间
会有这么大的差价吗?

仿照美心品牌制作
全都是“幽灵”公司
所以有记者了解到
原来这些所谓美心流心奶黄月饼
全部都是仿照品牌制作的!
记者通过三个不同的商家
购买了3份流心奶黄月饼
然后根据这三家商家注册的营业执照地址
到深圳和佛山实地探访
结果却发现它们全是“幽灵”公司!


假月饼也可扫码验证!
其实这些所谓“正品”月饼
一般都是通过微商或者电商进行出售

它们包装非常精美
不仅有烫金反光设计、
全套的标签信息、包装上还贴有防伪码
微信扫一下这个防伪码
跳出来的页面显示这是正品

但是如果用手机浏览器打开会发现
该网页的链接地址为
一串杂乱的组合
并非美心月饼官网

就在9月7日
海丰公安打掉了一个销售假冒月饼窝点
现场查获的1000余盒假冒品牌月饼
这个窝点销售的月饼包装
与记者买到的月饼包装高度相似!

经审查
犯罪嫌疑人于8月29日租下这间仓库
主要用于月饼的分装和销售
从9月3日至9月7日被抓获
他们共销售发往
汕头市假冒品牌月饼100箱
如果你现在有吃这些牌子月饼
就要小心了!

成本价不到40一盒
批发给微商100块
在深圳或汕头包装发货
能够卖到200多300一盒!
利润翻了近8倍!
所以不少黑心商家为了牟取暴利
铤而走险制作黑心假月饼!
真是太黑心了!

这样的月饼卫生不达标
可能会引起食物中毒!
记者将购买的3盒月饼
送往研究所分别检测

检测结果显示
有两个样品
出现了微生物超标的情况
其中有样品的菌落总数
超标超到270倍以上了
致病菌超标270倍
不仅可能会引起食物中毒
还说明它的卫生不达标

可想而知
这些黑心月饼
到底是在一个什么的工作环境上做出来

其实这些售假月饼
已经不是第一次的了
早几年
东莞就曾查获了一家假月饼窝点
现场环境让人作呕!

生产环境都是苍蝇!
看到这样的场面
你还敢贪便宜买这些月饼吗?

最后,再提醒各位街坊一句:
假冒月饼没有获得QS认证
生产环境差,使用劣质原料

正品外观油水充足
闻起来有浓香花生油味道
切开明显能看见蛋汁流出
但是假货掰开来
会发现非常的干
并没有出现像蛋黄一样流出来的流心

还是说一句
不要贪小便宜
去帮衬那些来路不明的月饼
想吃月饼记得去正规渠道购买哦!
【今日话题】
你买了哪家的月饼?
▎素材来源: 花样长沙、综合网络,如有侵权联系小编删除